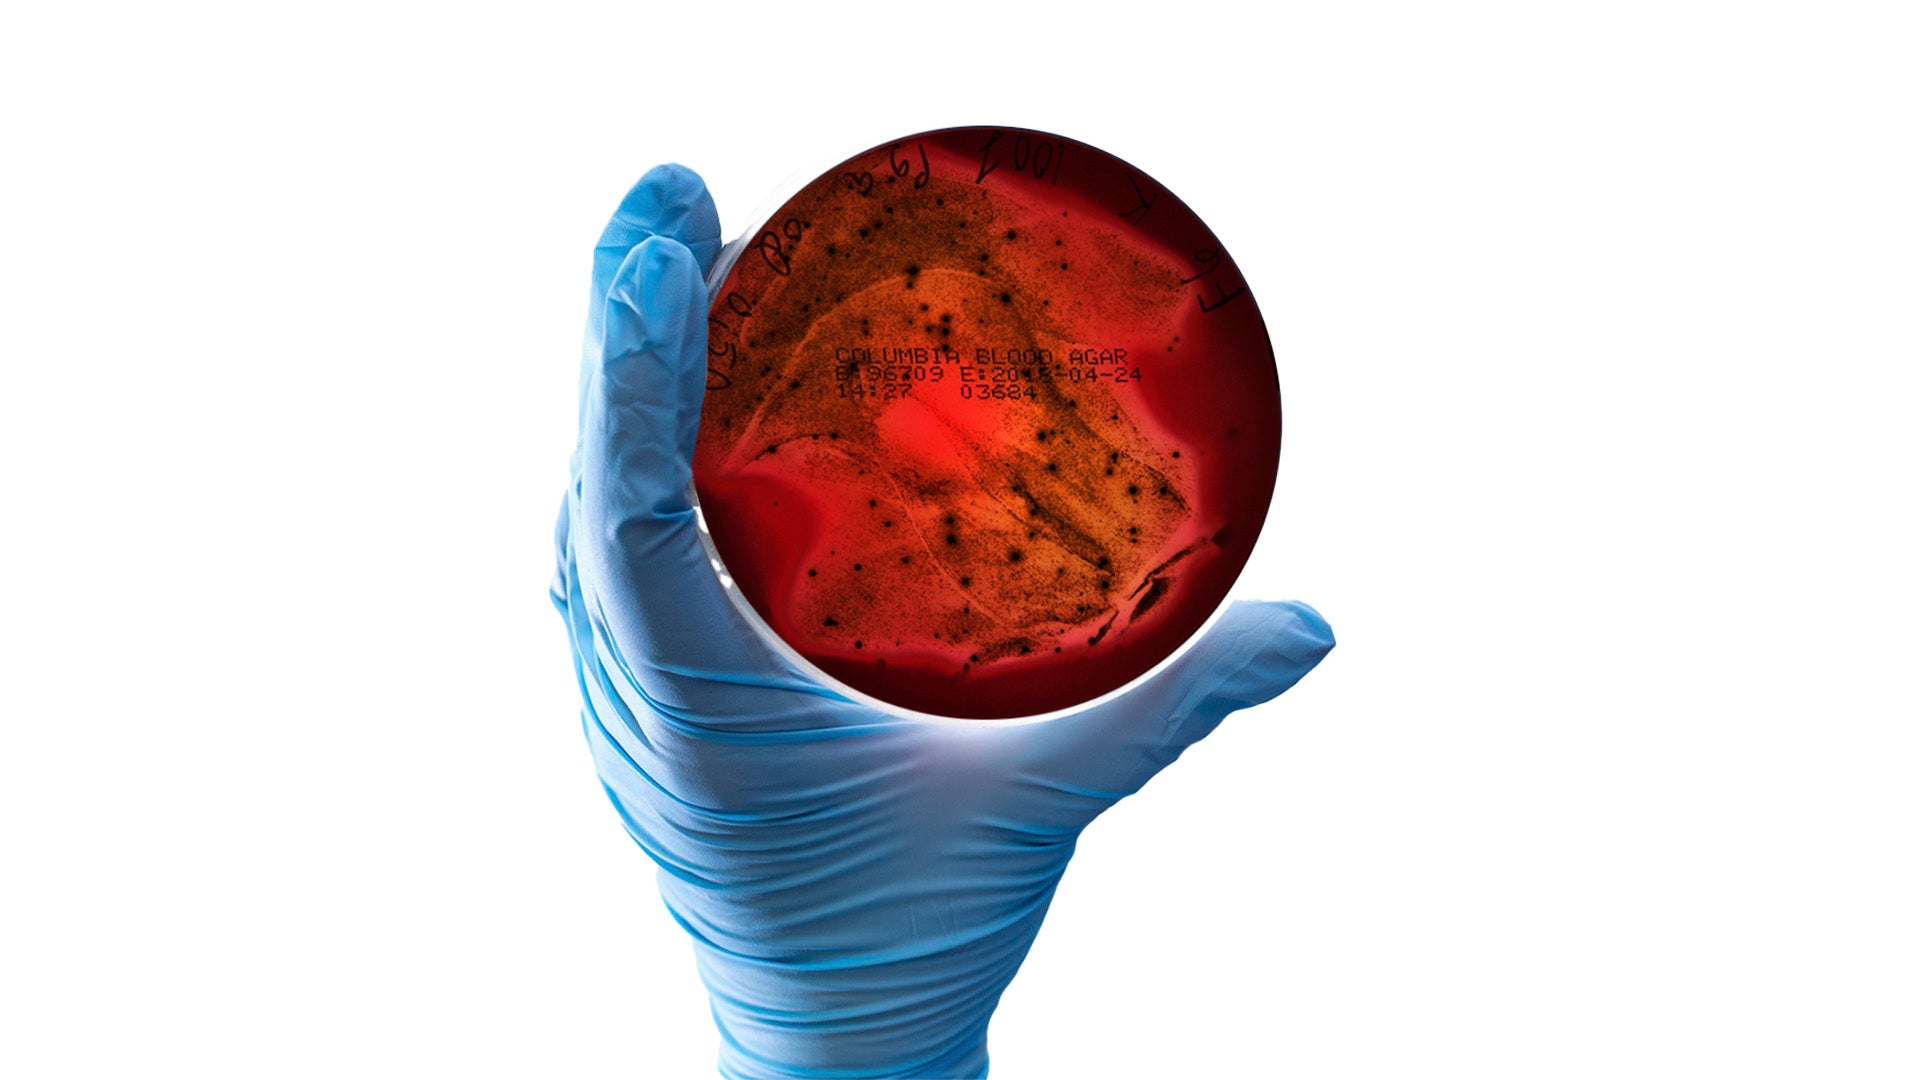
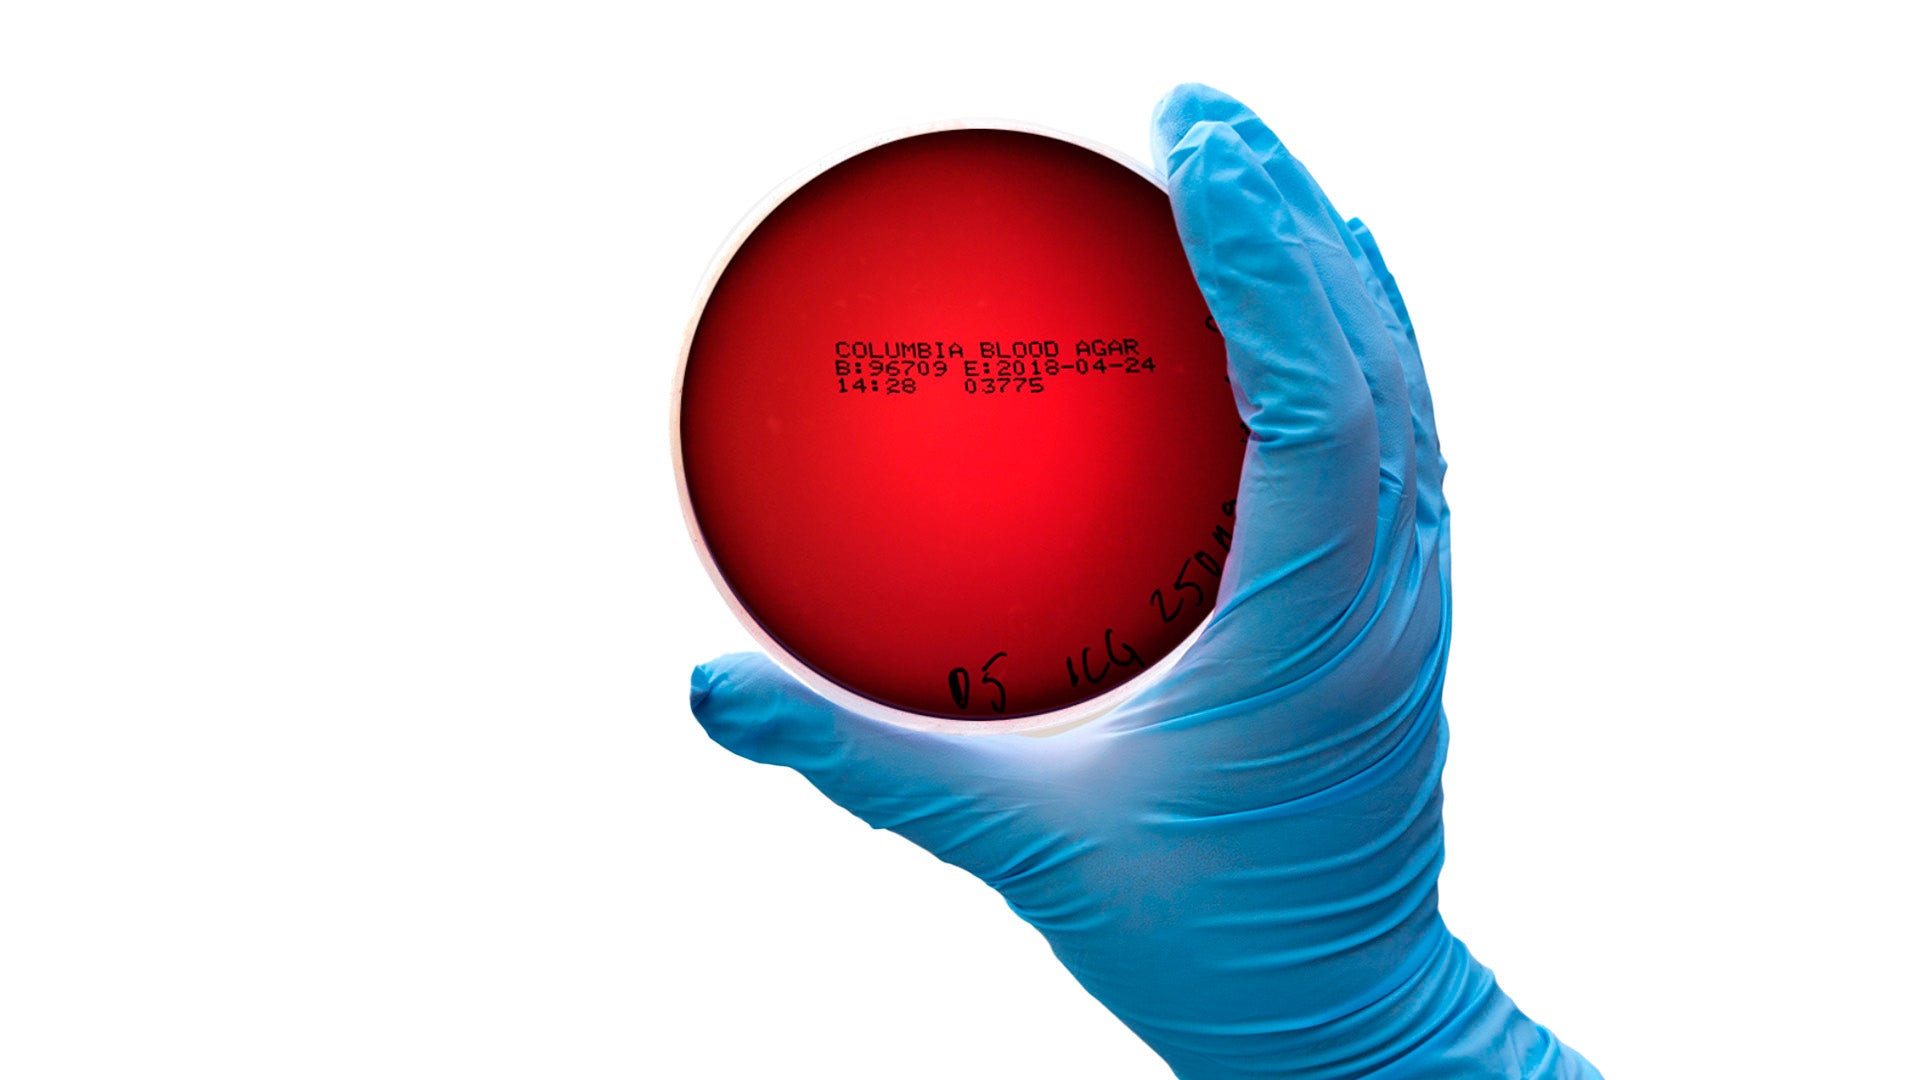

Sydänkirurgin missio
Vuonna 2016 sydänkirurgi Tommi Pätilä teki vaikeaa sydänleikkausta HUS-sairaalassa. Sydämestä otetut näytteet osoittivat, että ongelmien syy oli lähtöisin suun bakteereista. Pätilälle heräsi vahva tunne: jotain oli tehtävä. Hän ei enää koskaan halua joutua leikkaamaan sydäntä, joka kärsisi suusta peräisin olevista bakteereista.
Suun sairauksista 95 % on plakin aiheuttamia. Hammasharja on oiva keino torjumaan plakkia, mutta silläkin saa parhaimmillaan vain 50-65 % plakista poistettua. Pätilä ajatteli, että jäljelle jäävälle plakille olisi pakko tehdä jotain.

Suun huono hygienia tai ikenien tulehdus voi aiheuttaa bakteerien pääsyn verenkiertoon. Suussa elävät haitalliset mikrobit, kuten ientulehdusta aiheuttavat bakteerit, voivat tunkeutua verisuonten läpi, erityisesti tulehtuneiden kudosten kautta.

Bakteerit, jotka ovat päässeet verenkiertoon, voivat matkustaa koko kehon läpi. Verenkierron mukana ne voivat asettua eri elimiin, mutta sydän on erityisen altis, koska bakteerit voivat kiinnittyä sydämen sisäosiin, kuten läppiin tai kudoksiin, aiheuttaen tulehduksia.

Sydämeen päätyneet bakteerit voivat aiheuttaa vakavia terveysongelmia, kuten endokardiittia, eli sydämen sisäkalvon tulehdusta. Tämä tila voi vahingoittaa sydämen rakenteita ja johtaa vakaviin komplikaatioihin, erityisesti, jos tulehdusta ei havaita ajoissa.
Hyvä suunterveys ja säännöllinen suuhygieniasta huolehtiminen ovat ensisijaisia keinoja ehkäistä näitä riskejä ja suojella koko kehoa haitallisilta vaikutuksilta.
Suun huono hygienia tai ikenien tulehdus voi aiheuttaa bakteerien pääsyn verenkiertoon. Suussa elävät haitalliset mikrobit, kuten ientulehdusta aiheuttavat bakteerit, voivat tunkeutua verisuonten läpi, erityisesti tulehtuneiden kudosten kautta.
Bakteerit, jotka ovat päässeet verenkiertoon, voivat matkustaa koko kehon läpi. Verenkierron mukana ne voivat asettua eri elimiin, mutta sydän on erityisen altis, koska bakteerit voivat kiinnittyä sydämen sisäosiin, kuten läppiin tai kudoksiin, aiheuttaen tulehduksia.
Sydämeen päätyneet bakteerit voivat aiheuttaa vakavia terveysongelmia, kuten endokardiittia, eli sydämen sisäkalvon tulehdusta. Tämä tila voi vahingoittaa sydämen rakenteita ja johtaa vakaviin komplikaatioihin, erityisesti, jos tulehdusta ei havaita ajoissa.
Hyvä suunterveys ja säännöllinen suuhygieniasta huolehtiminen ovat ensisijaisia keinoja ehkäistä näitä riskejä ja suojella koko kehoa haitallisilta vaikutuksilta.




Lumoral auttaa
Tutkimukset ovat osoittaneet, että huolellinen harjaus markkinoiden tehokkaimmalla sähköhammasharjalla poistaa vain noin 65% suussa olevista haitallisista bakteereista.
Vaikka hampaiden harjaus ja hammasvälien puhdistus ovat suunhoidon kulmakivi, yksinään ne eivät usein riitä.
Paljain silmin näkymättömän jäännösplakin torjumiseksi suomalaiset tutkijat ovat kehittäneet valoaktivoitavan antibakteerisen hampaiden puhdistusmenetelmän, Lumoralin.
Tutkitusti tehokas
Lumoral-hoito on maailmanlaajuisesti täysin ainutlaatuinen, ja se on mullistanut hampaiden omahoidon laatua kansainvälisesti. Lukuisat julkaistut tutkimukset puhuvat hoidon puolesta. Lumoral poistaa 99,998 % plakin bakteereista jättäen samalla suun oman bakteerikannan rauhaan.
Vasemmalla on hoitamaton malja, jossa kasvaa Porphyromonas gingivalis -bakteeria, joka on yksi merkittävistä ientulehduksen ja suun terveysongelmien aiheuttajista. Oikealla on hoidettu malja, jossa bakteerikasvu on pysähtynyt Lumoral-laitteen avulla. Plakin bakteereilla voi olla yhteys sydänsairauksiin, erityisesti krooniseen tulehdukseen, ateroskleroosiin ja sydäninfarkteihin. Hyvä suuhygienia ja suun hoito voivat vähentää tätä riskiä ja edistää sydämen terveyttä.
Hoitamaton
Hoidettu

Helppo ja turvallinen käyttää
Suomen Suuhygienistiliitto ja hammaslääkärit suosittelevat Lumoralia suun omahoidon parantamiseen. Hoidon kesto on vain 10 minuuttia ja se tehdään kaksi kertaa viikossa ennen hampaiden harjausta.
Älä anna suunterveyden jäädä sattuman varaan – ota Lumoral käyttöön ja suojele sekä suusi että sydämesi.
Ammattilaiset suosittelevat

Suuhygienisti, yrittäjä, Sun Hymy
Hannele Nyfors
"Lumoral on tullut jäädäkseen! Upea tunne suussa jo yhden hoitokerran jälkeen. Liukkaat ja paljon puhtaammat hampaat verrattuna pelkkään hampaiden harjaamiseen ja välien puhdistamiseen. Ihan kuin olisi suuhygienistillä putsissa käynyt."

Suuhygienisti, tutkija, Hammasklinikka Kruunu
Hanna Lähteenmäki
"Lumoral-hoito tuo huomattavan lisän suun terveyden hoidolle kotona. Lumoral ennaltaehkäisee ja parantaa hammasimplantteja ympäröivän kudoksen tulehduksia ja edistää koko suun hyvinvointia."

Erikoishammasläääkäri / Lasten hammaslääkäri, Uusi lastensairaala, Helsinki Suu- ja leukakirurgian osasto, HUS
Heikki Alapulli
"Näen Lumoralin lupaavana hampaiden harjauksen, fluorin ja ksylitolin käytön ohella käytettävänä menetelmänä, joka voi tuoda lisäarvoa myös lasten suunterveyteen."